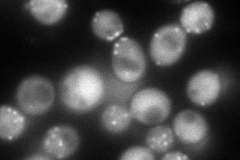
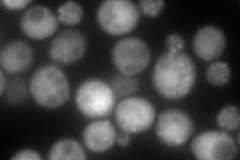

View description
Alpha subunit of the capping protein (CP) heterodimer (Cap1p and Cap2p) which binds to the barbed ends of actin filaments preventing further polymerization; localized predominantly to cortical actin patches
Localization:
Intensity:
Fold change:
Significance:
-
C’ GFP library in SD

punctate61 -
N' NOP1pr-GFP in SD
cytosol,punctate165.814 -
N' TEF2pr-mCherry in SD
punctate,bud neck173.278 -
N' NATIVEpr-GFP in SD

punctate,bud neck57.1964 -
N' TEF2pr-VC and Cyto-VN in SD

punctate,bud neck46.9549 -
C’ GFP library in SD+DTT

punctate94.651.55Yes -
C’ GFP library in SD+H2O2

punctate74.781.22No -
C’ GFP library in Starvation Media

punctate105.541.72Yes -
C’ GFP library on the background of Pup2-DaMP

punctate -
C’ GFP library on the background of CCT mutant

punctate74.31081.21799No
